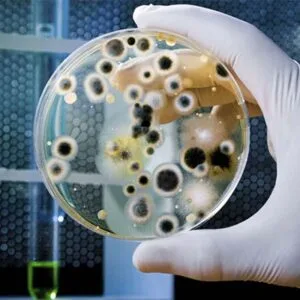
Αθανασάκη Μανιατάκη Μαρία

Σκουλάκης Μιχαήλ
Γενικός Γιατρός
Γενικός Ιατρός
Ιατρική κάλυψη όλο το 24hΚλινική εξέταση για όλη την οικογένειαΗλεκτρονική συνταγογράφηση/Έκδοση παραπεμπτικών για εργαστηριακές εξετάσεις/Αξιολόγηση αποτελεσμάτων
Βαρδαντώνη 2, Κίσσαμος

Ακτινολόγος - Ακτινοδιαγνώστης
Τσουρής Ν. Γεώργιος
Ιατρός Ακτινοδιαγνώστης
Υπερηχογραφήματα
Ακτινογραφίες
Triplex - Μαστογραφίες
Οστική Πυκνότητα (DEXA)
Ο/Η ιατρός δέχεται ραντεβού μέσω τηλεφώνου.

Γενικός Γιατρός
Γενικός Ιατρός

Οφθαλμίατρος
Οφθαλμίατρος - Παιδοφθαλμίατρος
Βιοπαθολόγος
Βιοπαθολόγος - Μικροβιολόγος